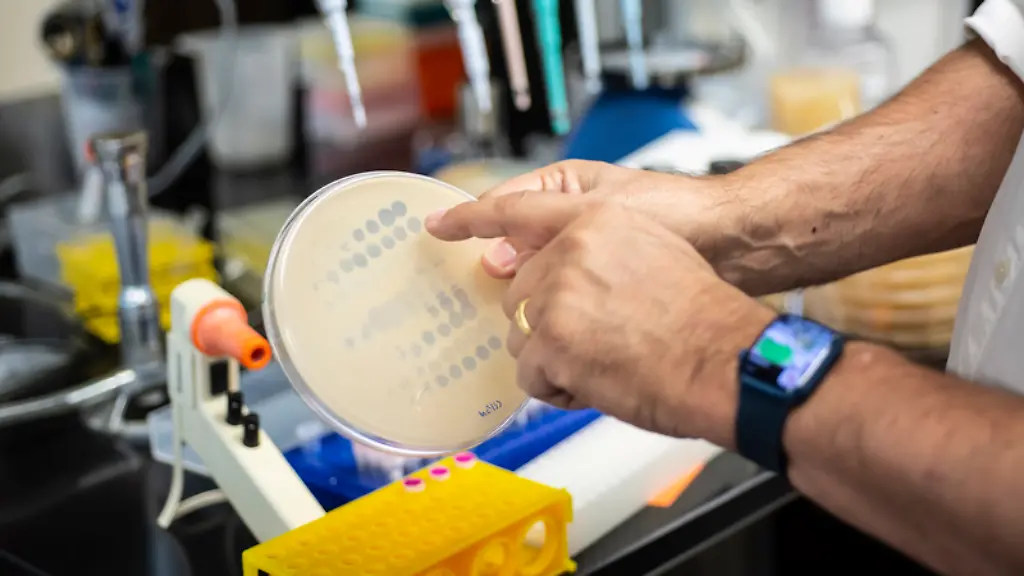
phagen

Wenn Antibiotika nicht wirkenPhagen helfen bei "Albtraum"-Infektionen
Immer häufiger reagieren bakterielle Erreger nicht mehr auf Antibiotika. Dann kann mitunter eine Phagen-Therapie helfen, wie eine Studie zeigt. In Deutschland wird derzeit eine klinische Untersuchung vorbereitet.
Eine Phagen-Therapie kann bei der Bekämpfung schwer zu therapierender bakterieller Infektionen helfen. In einer Studie behandelte ein internationales Forschungsteam insgesamt 20 Patienten mithilfe sogenannter Bakteriophagen - also Viren, die Bakterien abtöten. Alle Teilnehmer hatten überaus hartnäckige bakterielle Infektionen. Bei elf Patientinnen und Patienten sei die Therapie erfolgreich verlaufen, berichtet die Gruppe um Graham Hatfull von der University of Pittsburgh im Fachblatt "Clinical Infectious Diseases". Nebenwirkungen traten demnach nicht auf.
Holger Ziehr, Leiter der Pharmazeutischen Biotechnologie am Fraunhofer-Institut für Toxikologie und Experimentelle Medizin (ITEM) in Braunschweig, verweist auf das extrem heterogene Teilnehmerkollektiv der Studie, zu dem Kinder wie auch Erwachsene mit diversen Krankheitsbildern, komplexen Infektionen und unterschiedlichen Erregertypen zählten. Dass angesichts dieser Umstände mehr als die Hälfte der Teilnehmenden auf die Therapie angesprochen habe, sei beeindruckend, sagt der Experte, der nicht an der Arbeit beteiligt war. "Dieses Resultat lässt sich nicht wegdiskutieren."
Phagen bringen Bakterien zum Platzen
Bakteriophagen sind Viren, die Bakterien befallen. Dabei sind bestimmte Phagen auf einzelne Bakterienarten spezialisiert, oft sogar nur auf bestimmte Stämme einer Art. Die Viren dringen über spezielle Rezeptoren in die Bakterien ein und vermehren sich in der Zelle - bis die Masse neu produzierter Viren die Bakterienzelle zum Platzen bringt und damit abtötet.
Aufgrund ihrer extremen Spezialisierung zerstören Bakteriophagen bei der Therapie keine nützlichen Bakterien, etwa im Darm, und sie befallen auch keine Körperzellen. Andererseits muss für den bestimmten Erregerstamm eines Patienten ein jeweils passender Phage gefunden werden. Während die Phagen-Therapie in Ländern des früheren Ostblocks eine lange Tradition hat, wurde sie in westlichen Ländern nach dem Aufkommen der Antibiotika nicht mehr verfolgt.
Das ändert sich seit einigen Jahren - insbesondere wegen der zunehmenden Antibiotika-Resistenzen bakterieller Krankheitserreger. Studienleiter Hatfull hatte in den Vergangenheit Einzelfall-Studien mit vielversprechenden Resultaten veröffentlicht - jeweils bei Patienten, bei denen alle vorherigen Ansätze versagt hatten. Daraufhin hatte er Anfragen von Ärztinnen und Ärzten zu weltweit etwa 200 Patienten erhalten.
Antibiotikaresistente Mykobakterien
Daraus wählte das Team 20 Teilnehmer aus, die mit sogenannten Mykobakterien infiziert wurden, überwiegend Stämme der Art Mycobacterium abscessus. 16 Patienten hatten die Stoffwechselkrankheit Mukoviszidose, auch Cystische Fibrose (CF) genannt. Hier kann aufgrund eines Gendefekts der Schleim aus vielen Organen wie etwa der Lunge nicht mehr abfließen. Dadurch können sich Bakterien einnisten und unter anderem Entzündungen auslösen.
Für Ärztinnen und Ärzte seien Mycobacterium-abscessus-Infektionen ein Albtraum, wird Hatfull in einer Mitteilung seiner Universität zitiert. "Sie sind zwar nicht so häufig wie manch andere Infektionen, aber sie zählen zu denen, die sich am schwierigsten mit Antibiotika behandeln lassen."
Die Teilnehmenden, darunter Erwachsene wie auch Kinder über fünf Jahren, bekamen die - jeweils unterschiedlichen - Phagen entweder durch Injektion oder Inhalation, und zwar eine Milliarde Einheiten zweimal täglich über meist sechs Monate. Bei elf Probanden wertete das Team die Therapie als erfolgreich, bei vier Patienten stellte es keine Besserung fest, bei den übrigen fünf war das Resultat nicht eindeutig.
Keine Nebenwirkungen beobachtet
Die Medizinerinnen und Mediziner fanden keine Hinweise darauf, dass Erreger im Lauf der Therapie immun gegen die Phagen wurden. Zudem beobachteten sie keine Nebenwirkungen. "Das verschafft dem Eindruck beträchtliches Gewicht, dass die Therapie sicher ist", sagt Hatfull.
Unklar ist, warum die Behandlung bei manchen anschlug und bei anderen nicht. Möglicherweise hänge das mit den eingesetzten Phagen zusammen, sagt Hatfull. "Wir haben noch nicht herausgefunden, wie wir Phagen finden oder herstellen, die jeden Stamm dieser Patienten erwischen. Das bleibt eine der wichtigsten Herausforderungen für die Zukunft."
In Deutschland solle in der zweiten Jahreshälfte eine klinische Studie zur Phagen-Therapie beginnen, sagt der Braunschweiger Phagen-Experte Ziehr. Bei diesem - im Gegensatz zur aktuellen Studie - recht einheitlichen Teilnehmerkollektiv handelt es sich demnach ausschließlich um Mukoviszidose-Patienten, die mit dem Lungenkeim Pseudomonas aeruginosa infiziert sind. Sie bekommen einen Cocktail aus drei verschiedenen Phagen, die etwa 75 Prozent der P.-aeruginosa-Stämme abdecken. Erste Resultate erwartet Ziehr im Laufe des kommenden Jahres.